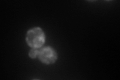
YJL080C
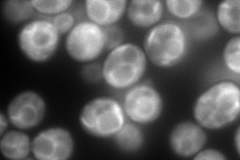
YJL080C
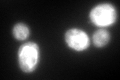
YJL080C
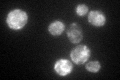
YJL080C

View description
Essential RNA-binding G protein effector of mating response pathway, mainly associated with nuclear envelope and ER, interacts in mRNA-dependent manner with translating ribosomes via multiple KH domains, similar to vertebrate vigilins
Localization:
Intensity:
Fold change:
Significance:
-
C’ GFP library in SD
ER248.89 -
N' NOP1pr-GFP in SD
cytosol,vacuole membrane421.214 -
N' TEF2pr-mCherry in SD

cytosol261.798 -
N' NATIVEpr-GFP in SD

ER99.6444 -
N' TEF2pr-VC and Cyto-VN in SD

#N/A0 -
C’ GFP library in SD+DTT
ER193.950.77No -
C’ GFP library in SD+H2O2

cytosolN/AN/ANo -
C’ GFP library in Starvation Media
ER131.950.53Yes -
C’ GFP library on the background of Pup2-DaMP

ER -
C’ GFP library on the background of CCT mutant

ER246.9920.992357No
